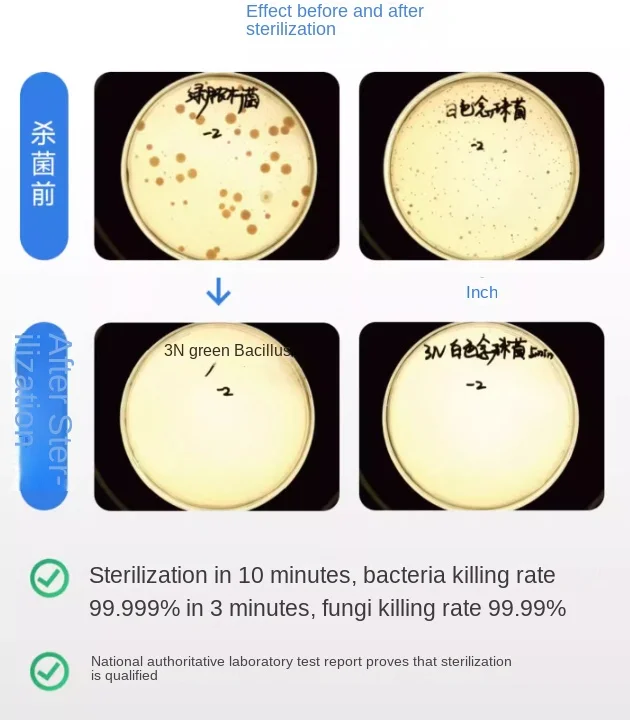

Контейнер для хранения роговичных линз с автоматической очисткой
Price history chart & currency exchange rate
Customers also viewed

$3.86
30 Pcs Dream Catcher Accessories Floral Hoop for Decoration DIY Cross Stitch Plastic Rings Metal Wreath Centerpiece
aliexpress.ru
$16.73
Для 2003-2007 Honda Accord двигатель центрального дверного замка двигатель универсального центрального дверного замка в комплекте мотор
aliexpress.com
$43.60
Led 12V 33000LM/2PCS Auto Lamps For Fiat Seicento/600 Cars 2000 2001 2002 2003 2004 2005 2006 2007 2008 2009 2010 Headlamp Bulbs
aliexpress.com
$242.81
Кремово-желтая вогнутая гитара, высококачественный пикап, кленовый гриф, Открытие нового магазина, очень низкая цена
aliexpress.com
$86.90
Сексуальное поступление, вечернее платье небесно-голубого цвета длиной ниже колена с рукавами-крылышками и цветочным принтом на заказ, для торжественных случаев
aliexpress.com
$7.80
Australia Smiggle Original Pencil Case Children's Clutch Bag Pencil Bag School Supplies Cartoon Cute Boy Stationery Cinosaur
aliexpress.com
$29.26
Hammock Mosquito Prevention Portable Outdoor Furniture Encrypted Mesh Nylon Spinning Wear Resistant Durable Camping Hiking Tour
aliexpress.com
$27.84
SEWS-Dog Pee Pads, Disposable Dogs Training Potty Pads,Pet Training Pads Strong Absorption Floor Mat
aliexpress.com
$11.84
Day Light 3-year Warraty 6000K IP65 LED Marker Ultra Bright for 06-07 BMW 5-series E60 M5 LED Angel Eyes Light
aliexpress.com
$24.50
BORX 4 pieces/set of terminal blades mold assembly customized terminal crimping machine knife
aliexpress.com
$16.49
Casual Chiffon O-neck Ruffled Long Sleeve Blouse Women Autumn Elegant Female Solid Loose Blouses Holiday Ladies Fashion Tops
aliexpress.com
$32.30
High Quality MS509 OBD2 EOBD Auto Detector Code Reader Auto Diagnosis Apparatus Reader Multi-language MS 509 full set
aliexpress.com
$588.05
Shark blue hot Injection For BMW S1000 S 1000 RR 1000RR 101No.2 S1000RR 09 10 11 12 13 14 2009 2010 2011 2012 2013 2014 Fairings
aliexpress.com
$11.86
Книга A Guide to Hindustani in Persian and Roman Characters: Specially Designed for the Use of Officers and Men Serving in India.
sima-land.ru
$10.27
Книга Le Portrait Du Xvie Siècle Aux Primitifs Français: Notes Et Corrections Au Catalogue Officiel Sur Cette Partie De L'expostion D'avril-Juillet 19
sima-land.ru
$10.48
Книга Art and industry in education. A book illustrative of the principles and problems of the courses in the fine and industrial arts at Teachers col
sima-land.ru
$16.97
Книга Département de l'Aube. Cahiers de doléances du bailliage de Troyes (principal et secondaires) et du bailliage de Barsur-Seine pour les États gén
sima-land.ru
$11.28
Книга Conversations on Sanctification: For the Use of Those who are Seeking Full Salvation
sima-land.ru
$11.52
Книга Melodia; a comprehensive course in sight-singing (solfeggio); the educational plan
sima-land.ru
$16.66
Книга Practical calculation of dynamo-electric machines. A manual for electrical and mechanical engineers and a textbook for students of electro-techn
sima-land.ru